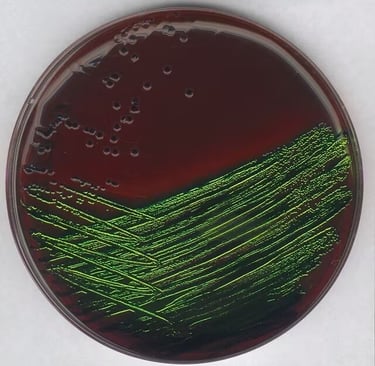

Guía Completa de Medios de Cultivo para Bacilos Gram Negativos
La precisión en el diagnóstico comienza con una selección acertada del medio de cultivo. Para facilitarte este proceso, he diseñado un Cuadro Comparativo detallado que resume el fundamento y los resultados esperados de los principales agares utilizados en el aislamiento de bacilos Gram negativos. ¡Descárgalo y llévalo a tu práctica!
2/26/20263 min read

Introducción
En el laboratorio de microbiología clínica, la identificación precisa de bacilos Gram negativos (BGN) es un pilar fundamental para el diagnóstico de enfermedades infecciosas. Desde enterobacterias comunes como Escherichia coli hasta patógenos más complejos como Salmonella spp. o no fermentadores como Pseudomonas aeruginosa, el éxito del aislamiento depende directamente de una selección técnica y acertada de los medios de cultivo.
Un error en la elección del agar o una mala interpretación de las colonias puede retrasar el inicio de un tratamiento antibiótico adecuado, comprometiendo la salud del paciente.
Los medios de cultivo para bacterias Gram negativas están diseñados bajo dos principios bioquímicos esenciales: la selectividad y la diferenciación.
Selectividad: Estos agares incorporan agentes inhibidores como sales biliares, desoxicolato de sodio o colorantes (cristal violeta, eosina, azul de metileno). Estos componentes tienen la función crítica de inhibir el crecimiento de la microbiota acompañante, principalmente bacterias Gram positivas, permitiendo que solo los bacilos Gram negativos logren desarrollar colonias visibles.
Diferenciación: Una vez que la bacteria crece, el medio nos "habla" a través de cambios de color. Esto se logra mediante la inclusión de carbohidratos (generalmente lactosa) y un indicador de pH (como el rojo neutro o el azul de bromotimol). Cuando una bacteria fermenta el azúcar, produce ácidos que bajan el pH, haciendo que el indicador cambie de color y permitiéndonos diferenciar a primera vista una bacteria fermentadora de una no fermentadora.
¿Quieres tener toda esta información organizada para tu práctica de laboratorio?
Descarga aquí mi Cuadro Comparativo de Cultivos para Gram Negativas en formato PDF."
La lectura de placas no es solo observar un cambio de color; es un arte técnico. En medios como el Agar MacConkey, debemos diferenciar entre fermentadores rápidos de lactosa (colonias rosadas intensas como E. coli) y fermentadores lentos o no fermentadores (colonias incoloras o transparentes como Salmonella o Shigella). Observar la presencia de moco (colonias mucoides) puede orientarnos hacia microorganismos como Klebsiella pneumoniae, mientras que el tamaño y el borde de la colonia nos dan pistas sobre la pureza del cultivo.
Consejos de Oro en el Laboratorio
Como profesionales, sabemos que la fase analítica está llena de variables. Un consejo vital es nunca interpretar las pruebas bioquímicas o la morfología en placas que tengan más de 24 horas de incubación, ya que el agotamiento de los nutrientes o el cambio excesivo de pH puede dar resultados falsos negativos. La observación macroscópica es el primer paso para un diagnóstico certero.


El Fundamento de la Selectividad y Diferenciación


Interpretación de la Morfología Colonial
En Agar MacConkey se diferencian entre fermentadores rápidos de lactosa, fermentadores lentos o no fermentadores
📖 Recomendación: Si quieres profundizar, te sugiero el Murray de Microbiología Médica
"Como Afiliada de Amazon, percibo dinero con las compras elegibles."
Conocimiento
Difundimos ciencia en microbiología y laboratorio clínico.
Recursos
Contacto
info@microbioonline.com
© 2026 Microbioonline. Todos los derechos

